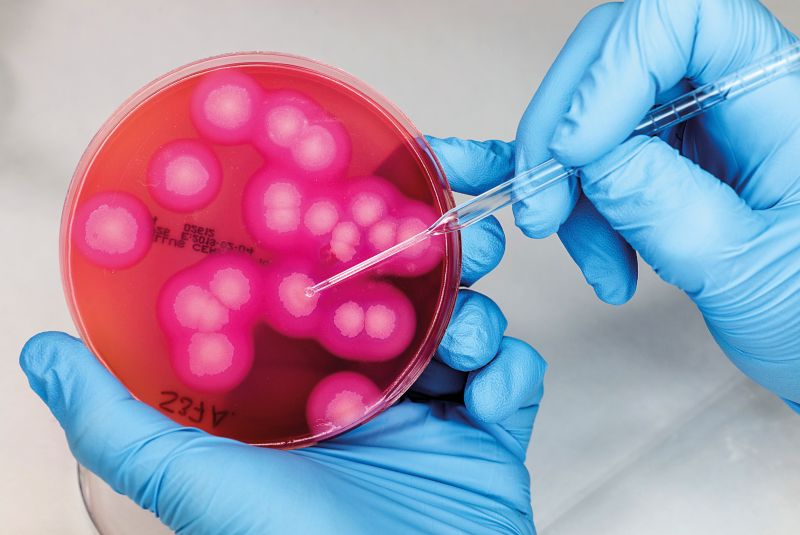
Diez años de AENOR Laboratorio

Menú Principal
 LA REVISTA DE LA EVALUACIÓN DE LA CONFORMIDAD
LA REVISTA DE LA EVALUACIÓN DE LA CONFORMIDAD
- Certificados para una gestión integral en sanidadLas certificaciones, específicas sanitarias y otras generalistas, ponen el foco en el paciente
- Delegado de Protección de Datos, el profesional más buscadoAENOR certifica a los primeros DPD
- Diez años de AENOR LaboratorioMás de 700.000 análisis realizados
- Entrevista a Paloma GarcíaResponsable de Calidad y Medio Ambiente de Adecco
- Doble certificación para la seguridad de la información en Red.esCasos Prácticos / Servicios
De un Vistazo